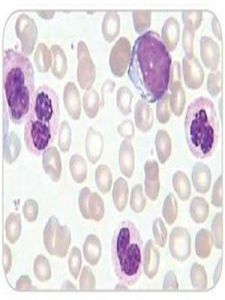
白細胞酯酶

特徵
但這種酶類只在中性粒細胞記憶體在,其它的細胞內則沒有,所以不能檢測其它類型的白細胞,只能檢測中性粒細胞,也就是通過常說的炎性細胞。這個結果陽性說明所檢測的
白細胞酯酶判斷標準
唾液酸苷酶活性陰性可以排除細菌性陰道炎。
清潔度2度,說明陰道有炎症。
H2O2陰性,H2O2(過氧化氫)它是乳酸桿菌的代謝產物!而乳酸桿菌是優生菌,它的含量應該是越高越好的!
白細胞酯酶是人體白細胞內含有的一種特異性酶類,臨床常用這種酶類來檢測標本中有無白細胞存在。
但這種酶類只在中性粒細胞記憶體在,其它的細胞內則沒有,所以不能檢測其它類型的白細胞,只能檢測中性粒細胞,也就是通過常說的炎性細胞。這個結果陽性說明所檢測的
白細胞酯酶唾液酸苷酶活性陰性可以排除細菌性陰道炎。
清潔度2度,說明陰道有炎症。
H2O2陰性,H2O2(過氧化氫)它是乳酸桿菌的代謝產物!而乳酸桿菌是優生菌,它的含量應該是越高越好的!
尿白細胞酶是尿檢常規檢查項目之一。
簡介血細胞中所含酯酶各不一致,但皆系作用於短鏈脂肪酸的酯酶,統稱非特異性酯酶。其顯示方法是採用偶氮偶聯法。由於提供水解的基質不同,血細胞中常見酯酶有以下幾種...
非特異性酯酶染色目前臨床套用的阿德福韋酯是阿德福韋的前體,在體內水解為阿德福韋發揮抗病毒作用。阿德福韋酯是5’-單磷酸脫氧阿糖腺苷的無環類似物。 隨機雙盲安慰劑對照的臨...
含量測定 合成路線 說明書 最新研究 廠家介紹葡萄糖腦苷脂酶缺乏症(Gauchers disease,GD)是溶酶體貯積病(lysosomal storage disease,LSD)中最常見的一種...
概述 疾病名稱 英文名稱 別名 分類受體酪氨酸磷酯酶為單次跨膜蛋白受體,受體胞內區具有蛋白酪氨酸磷酯酶的活性,胞外配體與受體結合激發該酶活性,它的作用不是簡單的與RPTK相反,可能與酪氨酸...
介紹甲孕環酯為長效孕激素,肌注後貯存在肌肉組織中逐步緩慢釋放而發揮長效避孕作用。其主要作用為抑制排卵、影響宮頸粘液稠度和抑制子宮內膜生長發育。
基本資料 功用作用 作用機理 生理功能 對月經的影響第一,該法只需通過顏色的改變就可判定陰道炎的有無,可最大程度的降低人為因素的干擾,同時並不降低它的準確性(與陰道清潔度檢測有較高的符合率)。 因此,廣大...
簡介 相關介紹 參考資料頭孢呋辛酯顆粒,適用於敏感細菌引起的下列感染:1.上呼吸道感染:包括化膿性鏈球菌引起咽炎、扁桃體炎;肺炎鏈球菌、嗜血流感桿菌(包括產β-內醯胺酶的菌株)...
成份 性狀 適應症 規格 用法用量